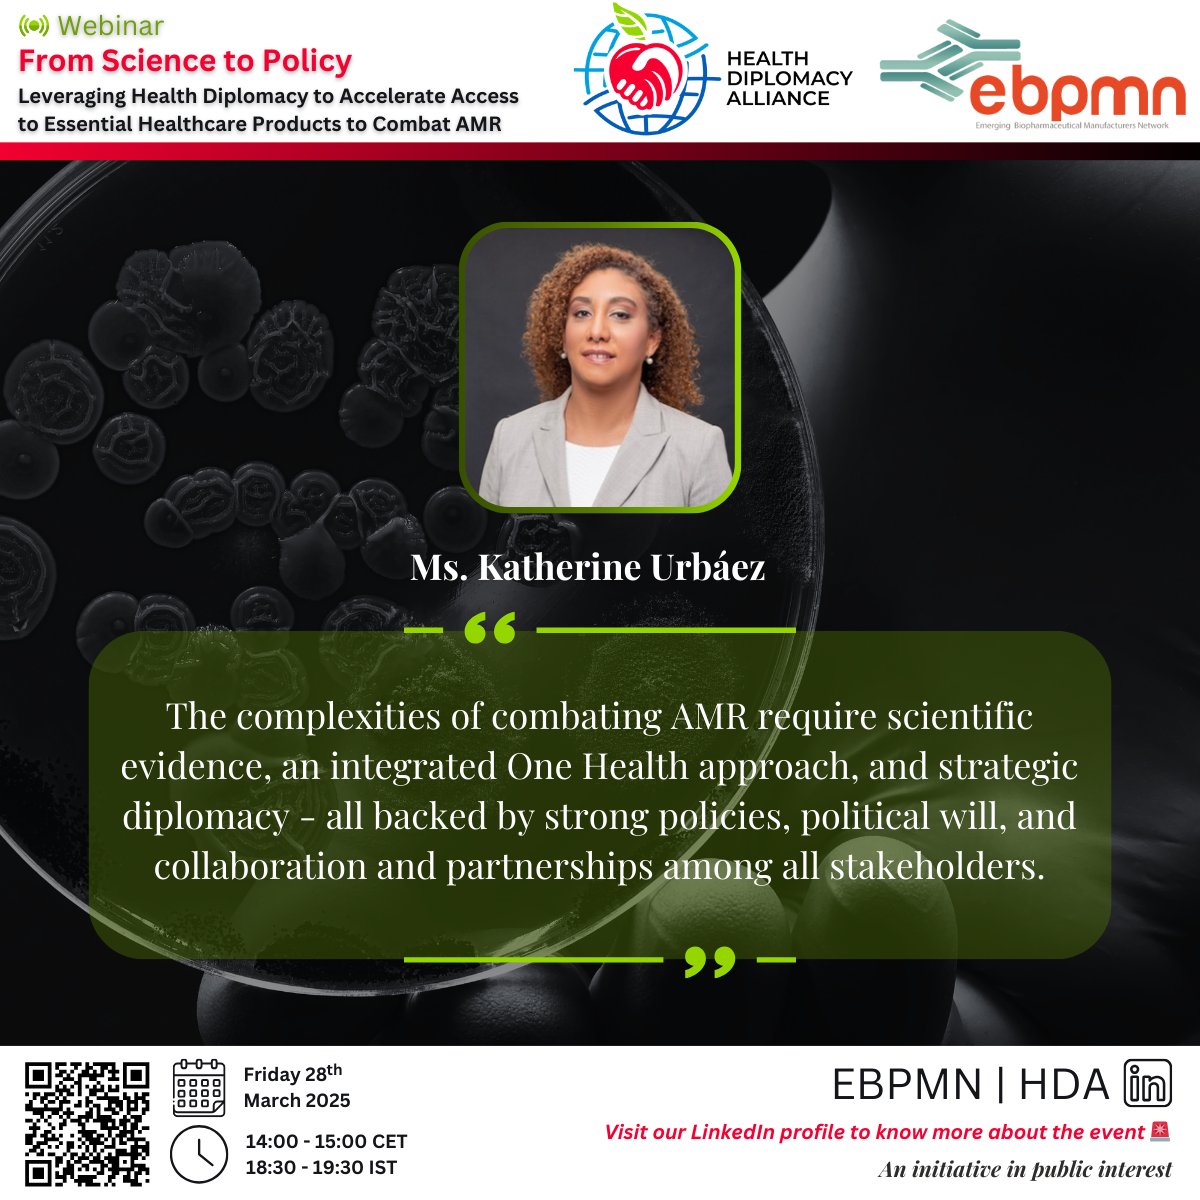
We're hosting a webinar with <a href="/HealthDiploA/">Health Diplomacy Alliance</a> for #awareness, #policies, &amp; #advocacy on #AntimicrobialResistance! 
🗓️March 28 2025 - 14:00 CET | 18:30 IST   
Register using zoom.us/webinar/regist… or scan the code below!
<a href="/AMRAlliance/">AMR IndustryAlliance</a> <a href="/reactgroup/">ReAct - Action on Antibiotic Resistance</a> <a href="/AMRActionFund/">AMR Action Fund</a> <a href="/gatesfoundation/">Gates Foundation</a> <a href="/WHO/">World Health Organization (WHO)</a>

EBPMN
@ebpmn
ID: 1761987092794716160
26-02-2024 05:30:53
11 Tweet
8 Followers
9 Following

EBPMN is dedicated to making biopharmaceuticals accessible in middle-income countries, leveraging local manufacturing to improve medical care and address health concerns. Instituto Butantan @biovac Zydus Lifesciences Ltd. Techinvention Lifecare Panacea Biotec #biopharmaceuticals #biosimilars


An interesting read on the 'Current Status of Biosimilars and Their Impact on Pharmacovigilance' Source: Pharmaceutical Executive pharmexec.com/view/current-s…




We're hosting a webinar with Health Diplomacy Alliance for #awareness , #policies, and #advocacy on #AntimicrobialResistance! 🗓️March 28, 2025 - 14:00 CET | 18:30 IST Register using zoom.us/webinar/regist… or scan the code below!


We're hosting a webinar with Health Diplomacy Alliance for #awareness, #policies, & #advocacy on #AntimicrobialResistance! 🗓️March 28 2025 - 14:00 CET | 18:30 IST Register using zoom.us/webinar/regist…… or scan the code below! AMR IndustryAlliance ReAct - Action on Antibiotic Resistance AMR Action Fund Gates Foundation World Health Organization (WHO)


We're hosting a webinar with Health Diplomacy Alliance for #awareness, #policies, & #advocacy on #AntimicrobialResistance! 🗓️March 28 2025 - 14:00 CET | 18:30 IST Register using zoom.us/webinar/regist………or scan the code below! AMR IndustryAlliance ReAct - Action on Antibiotic Resistance AMR Action Fund Gates Foundation World Health Organization (WHO)


We're hosting a webinar with Health Diplomacy Alliance for #awareness, #policies, & #advocacy on #AntimicrobialResistance! 🗓️March 28 2025 - 14:00 CET | 18:30 IST Register using zoom.us/webinar/regist… or scan the code below! AMR IndustryAlliance ReAct - Action on Antibiotic Resistance AMR Action Fund Gates Foundation World Health Organization (WHO)

🔔#WebinarAlert! In collab with Third World Network 📅 25 Apr 2025 |14:00–15:00 CET |18:30–19:30 IST 🔗 Register: lnkd.in/dhHwJMjg or Scan code Biosimilars Forum Biosimilar News pharmaphorum Genetic Engineering & Biotechnology News #Biosimilars #Biopharma #Industry #Regulatory


🔔#WebinarAlert! In collab with Third World Network 💡Speaker Spotlight: Mr. KM Gopakumar 📷 25 Apr 2025 |14:00–15:00 CET |18:30–19:30 IST 📷lnkd.in/dhHwJMjg or Scan code Biosimilars Forum Biosimilar News pharmaphorum Genetic Engineering & Biotechnology News #Biosimilars #Biopharma #Industry #Regulatory






